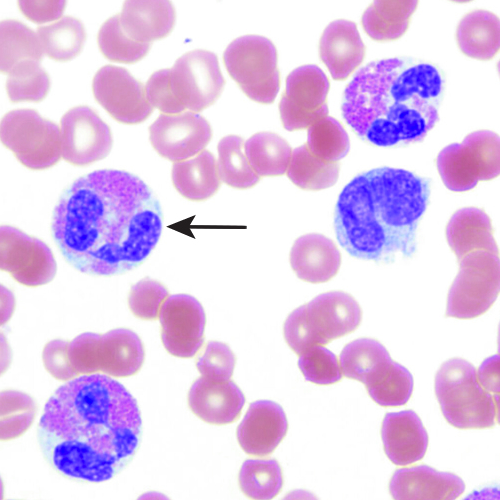
Cells

Digital Pathology and Eosinophil Detection
 There is growing interest in pathology in analyzing digital slides of eosinophil cells. Unfortunately for pathologists, this is a time-consuming process to complete by hand.
There is growing interest in pathology in analyzing digital slides of eosinophil cells. Unfortunately for pathologists, this is a time-consuming process to complete by hand.
The intent of this project is to design and implement an algorithm that will receive a digitized slide of human nasal tissue and output the density of the eosinophil cells in the slide. Digital slides are obtained through a collaboration with the Pathology department at the University of Pennsylvania.